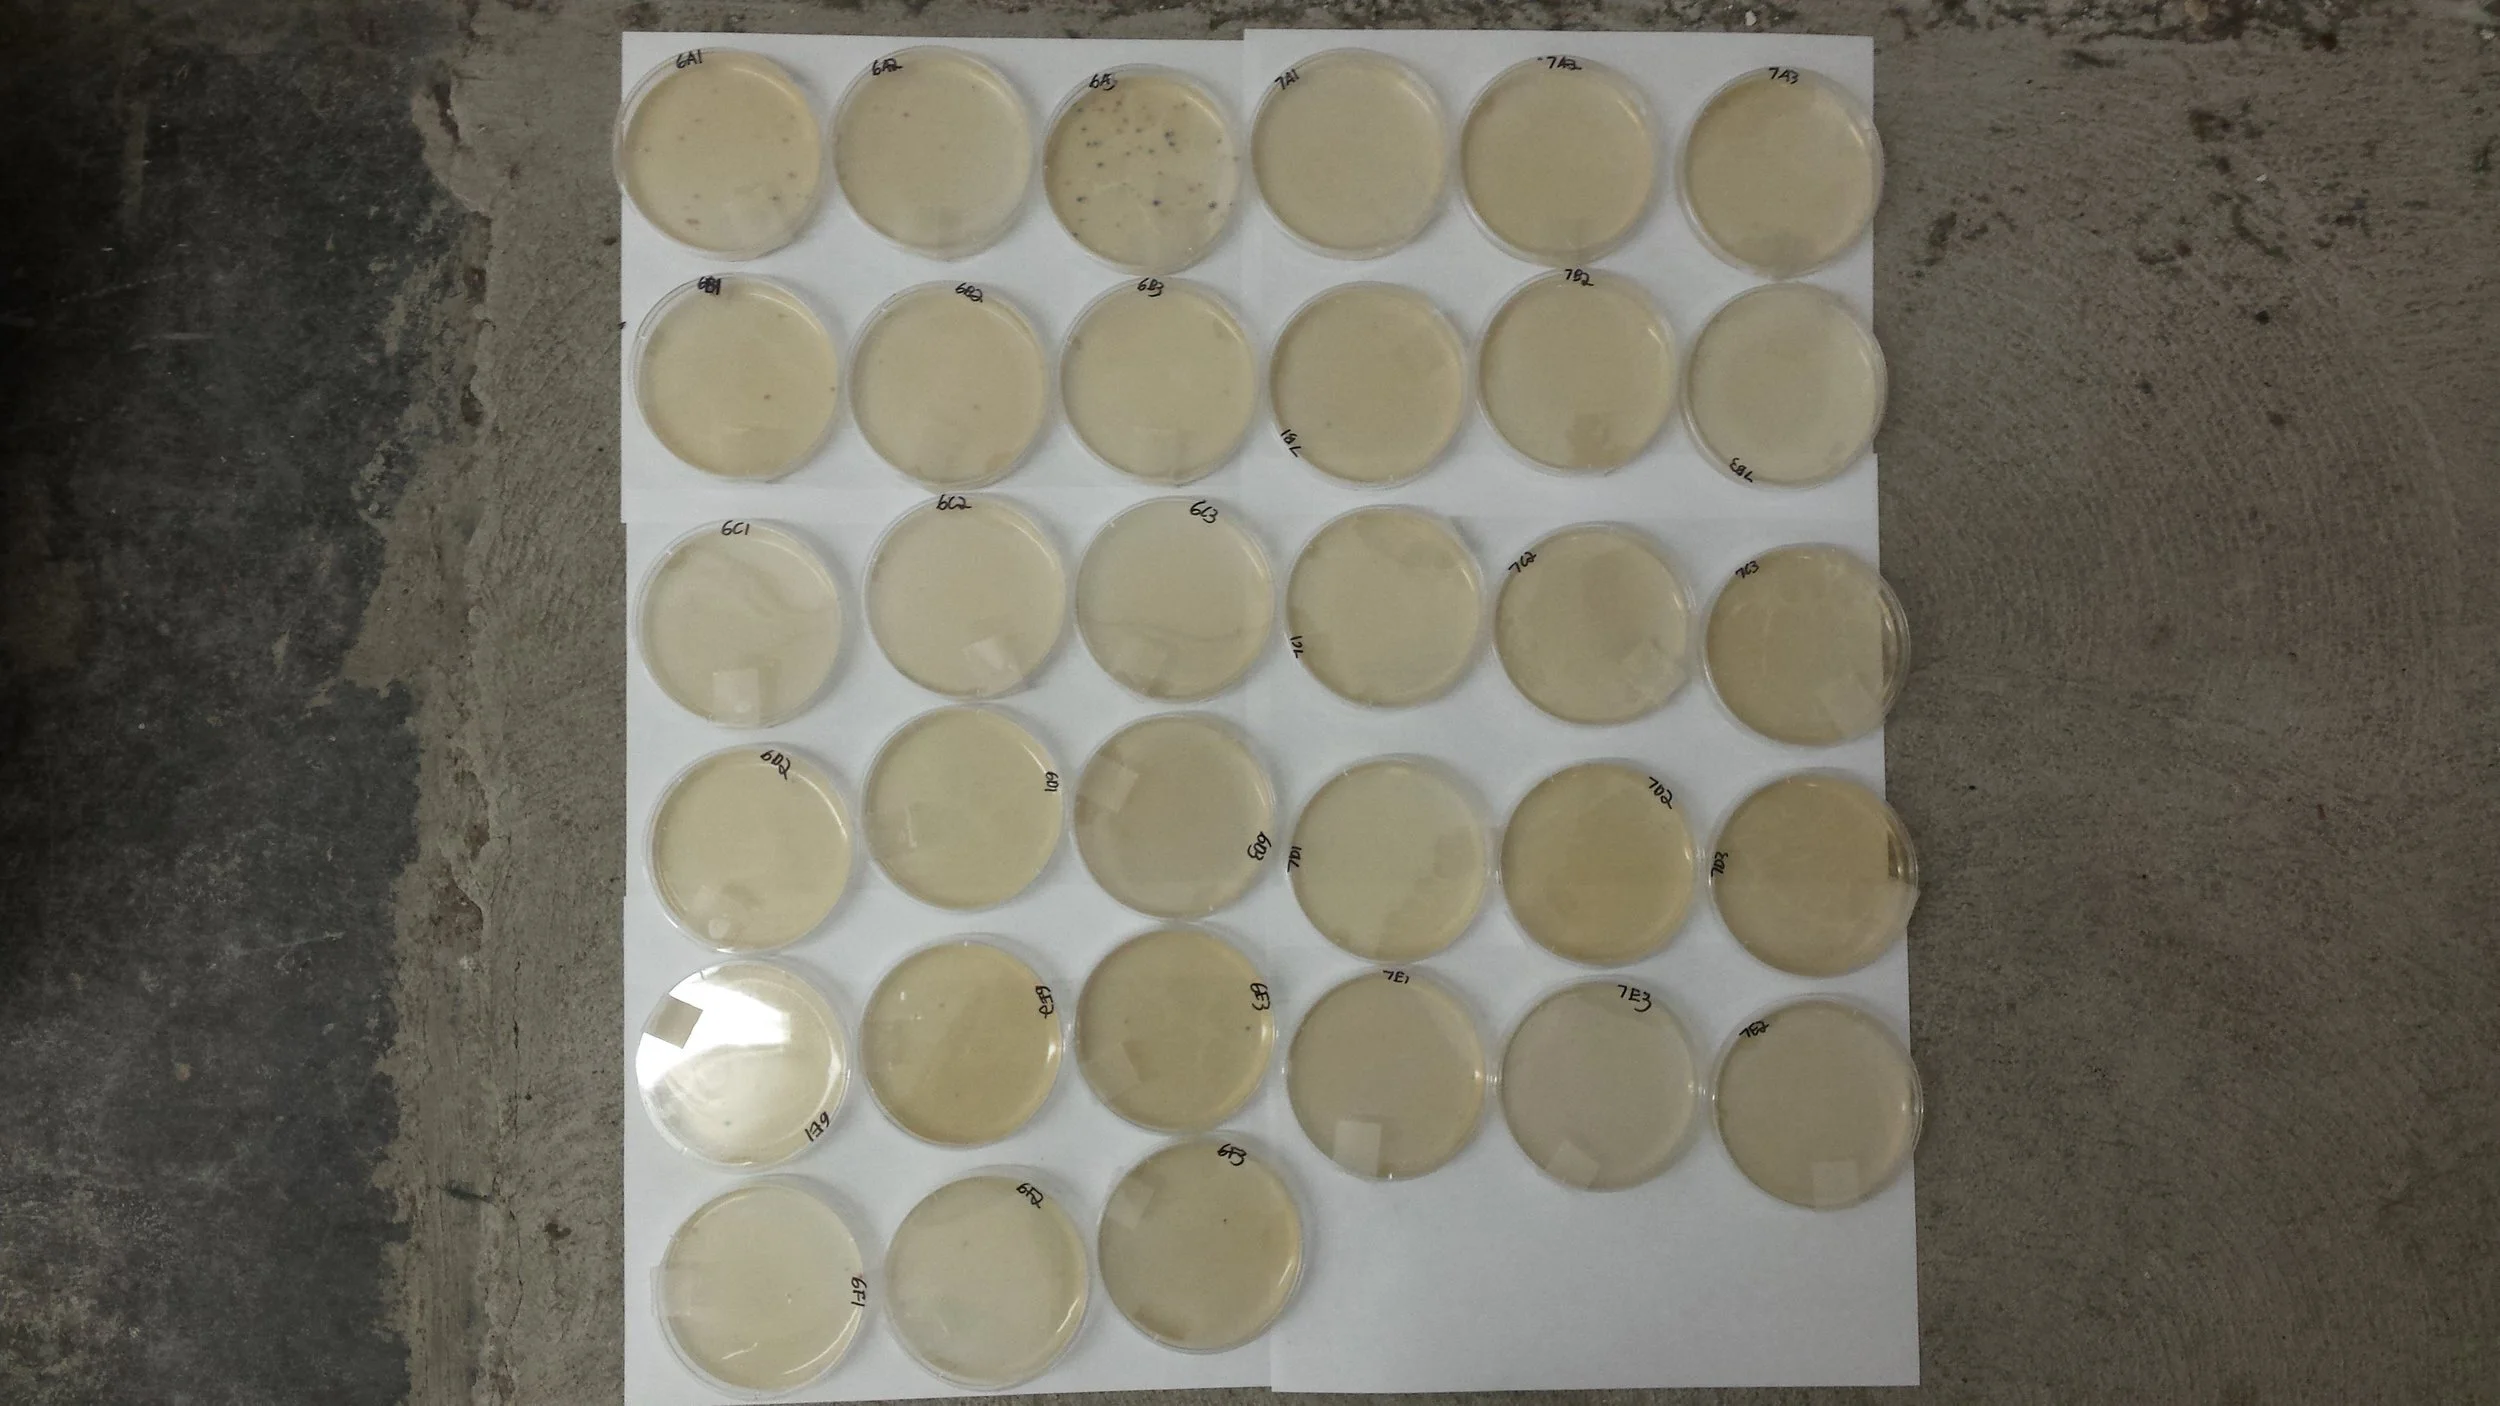

Toronto Harbour update: E. coli levels have dropped
Pier 4 Marina. The green water is a welcome sight. Photo by Lake Ontario Waterkeeper.
In recent weeks we have shared some off-the-charts sample results from the Toronto Harbour. Five straight sampling trips to Pier 4 Marina produced E. coli numbers so high we couldn’t properly determine the amount, leaving us to designate them as “too numerous to count.” In other words, at least 30 times more bacteria than accepted government guidelines for boating, and 300 times higher for swimming.
You can count the historic levels of rain in April and the beginning of May as a major player behind these bacteria results.
This week, however, has been a different story. Very little rain has fallen since May 5, and our samples were clean.
Samples after 24 hours of incubation. With a few exceptions, most contain no sign of E. coli. Photo by Lake Ontario Waterkeeper.
Every sample taken from the slip by the Harbourfront Canoe and Kayak Centre contained no E. coli bacteria whatsoever. This does not come as a surprise. This slip has been relatively clean since our sampling program picked up again back in January and we have seen zeroes before.
Pier 4 Marina is the real story here. Most samples came back with no sign of E. coli, something we haven’t seen since February.
In a recent blog we stated how on one trip “we didn’t need to sample Pier 4 Marina to know the water quality was bad.” It was a different story this week. When we sampled On May 10, the smell of sewage was gone. The water was dark green, a welcome sight after weeks of brown, murky water.